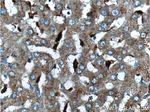
CPVL Antibody in Immunohistochemistry (Paraffin) (IHC (P))

Search
Proteintech
CPVL Polyclonal Antibody
{{$productOrderCtrl.translations['antibody.pdp.commerceCard.promotion.promotions']}}
{{$productOrderCtrl.translations['antibody.pdp.commerceCard.promotion.viewpromo']}}
{{$productOrderCtrl.translations['antibody.pdp.commerceCard.promotion.promocode']}}: {{promo.promoCode}} {{promo.promoTitle}} {{promo.promoDescription}}. {{$productOrderCtrl.translations['antibody.pdp.commerceCard.promotion.learnmore']}}
产品信息
12548-1-AP
种属反应
宿主/亚型
分类
类型
抗原
偶联物
形式
浓度
规格
纯化类型
保存液
内含物
保存条件
运输条件
产品详细信息
Immunogen sequence: YVVTSNMTL RDRDFPWTTT LSMLYIDNPV GTGFSFTDDT HGYAVNEDDV ARDLYSALIQ FFQIFPEYKN NDFYVTGESY AGKYVPAIAH LIHSLNPVRE VKINLNGIAI GDGYSDPESI IGGYAEFLYQ IGLLDEKQKK YFQKQCHECI EHIRKQNWFE AFEILDKLLD GDLTSDPSYF QNVTGCSNYY NFLRCTEPED QLYYVKFLSL PEVRQAIHVG NQTFNDGTIV EKYLREDTVQ SVKPWLTEIM NNYKVLIYNG QLDIIVAAAL TERSLMGMDW KGSQEYKKAE KKVWKIFKSD SEVAGYIRQV GDFHQVIIRG GGHILPYDQP LRAFDMINRF IYGKGWDPYV G (127-476 aa encoded by BC016838)
靶标信息
The protein encoded by this gene is a carboxypeptidase and bears strong sequence similarity to serine carboxypeptidases. Carboxypeptidases are a large class of proteases that act to cleave a single amino acid from the carboxy termini of proteins or peptides. The exact function of this protein, however, has not been determined.
仅用于科研。不用于诊断过程。未经明确授权不得转售。
篇参考文献 (0)
生物信息学
蛋白别名: carboxypeptidase WUG; Carboxypeptidase, vitellogenic-like; CP-Mac; CP-Mac carboxypeptidase; Probable serine carboxypeptidase CPVL; serine carboxypeptidase; tcag7.235; unnamed protein product; VCP-like protein; Vitellogenic carboxypeptidase-like protein
基因别名: 4933436L16Rik; CPVL; HVLP; PSEC0124; UNQ197/PRO223; VLP
UniProt ID: (Human) Q9H3G5, (Rat) Q4QR71, (Mouse) Q9D3S9
Entrez Gene ID: (Human) 54504, (Rat) 502774, (Mouse) 71287